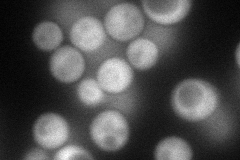
YNL074C
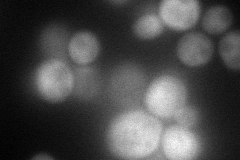
YNL074C
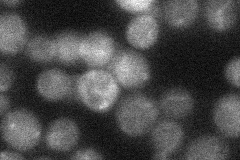
YNL074C
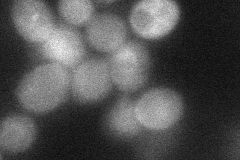
YNL074C
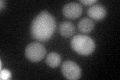
YNL074C
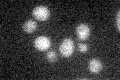
YNL074C

View description
Serine-rich protein of unknown function, predicted to be palmitoylated; overproduction suppresses the growth inhibition caused by exposure to the immunosuppressant leflunomide
Localization:
Intensity:
Fold change:
Significance:
-
C’ GFP library in SD

cytosol22.07 -
N' NOP1pr-GFP in SD
cytosol79.4658 -
N' TEF2pr-mCherry in SD
cytosol65.4223 -
N' NATIVEpr-GFP in SD
below threshold21.3809 -
N' TEF2pr-VC and Cyto-VN in SD
cytosol39.6197 -
C’ GFP library in SD+DTT
cytosol24.731.12No -
C’ GFP library in SD+H2O2

cytosol23.061.04No -
C’ GFP library in Starvation Media
cytosol20.670.93No -
C’ GFP library on the background of Pup2-DaMP

cytosol -
C’ GFP library on the background of CCT mutant

cytosol20.76740.940579No
